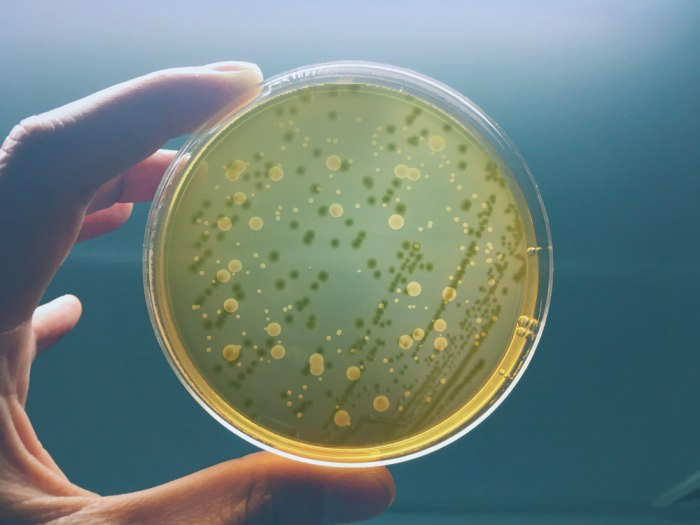
黃綠弧菌.jpg

NEWS CENTER
新聞中心
在這里您可以了解瑞森新材企業(yè)動態(tài)
NEWS CENTER
新聞中心
在這里您可以了解瑞森新材企業(yè)動態(tài)
讓納米銀水溶液幫您解決水產(chǎn)養(yǎng)殖因細菌引起的各種問題!
[ 時間:2023-07-24 閱讀:1606次 來源:] TAG: 水產(chǎn)養(yǎng)殖 水產(chǎn)抗菌溶液 納米銀抗菌溶液 抗菌劑
水產(chǎn)養(yǎng)殖過程中,有害細菌是常見的問題之一。這些細菌會感染水體,引起各種疾病和問題,嚴(yán)重影響水產(chǎn)養(yǎng)殖的產(chǎn)量和質(zhì)量。為了解決這些問題,許多水產(chǎn)養(yǎng)殖戶會使用各種抗菌劑來防止和治療這些有害細菌。然而,這些傳統(tǒng)抗菌劑在使用過程中存在一些問題,例如殘留可能對生態(tài)環(huán)境產(chǎn)生負面影響,殘留可能對人類健康產(chǎn)生影響等。

相比傳統(tǒng)抗菌劑,納米銀水溶液具有更強的抗菌能力,能夠更有效地解決因有害細菌引起的各種問題。納米銀水溶液中的納米銀離子可以破壞病原體細胞膜和DNA,對多種病原體有效,具有廣譜抗菌作用。同時,納米銀水溶液無殘留,不污染水質(zhì),生態(tài)影響小,對養(yǎng)殖生物安全,無毒副作用。
在實際應(yīng)用中,納米銀水溶液可以用于水產(chǎn)養(yǎng)殖、觀賞魚等水體環(huán)境的抗菌防病處理。它可以有效防止疾病傳播,提高水產(chǎn)養(yǎng)殖的產(chǎn)量和質(zhì)量。同時,使用納米銀水溶液還可以減少傳統(tǒng)抗菌劑的使用,降低對環(huán)境和養(yǎng)殖生物的負面影響。

福建瑞森新材料股份有限公司生產(chǎn)的水產(chǎn)養(yǎng)殖專用納米銀水溶液是一種安全、有效的抗菌劑,可以幫助水產(chǎn)養(yǎng)殖戶解決因有害細菌引起的各種問題,提高水產(chǎn)養(yǎng)殖的產(chǎn)量和質(zhì)量。